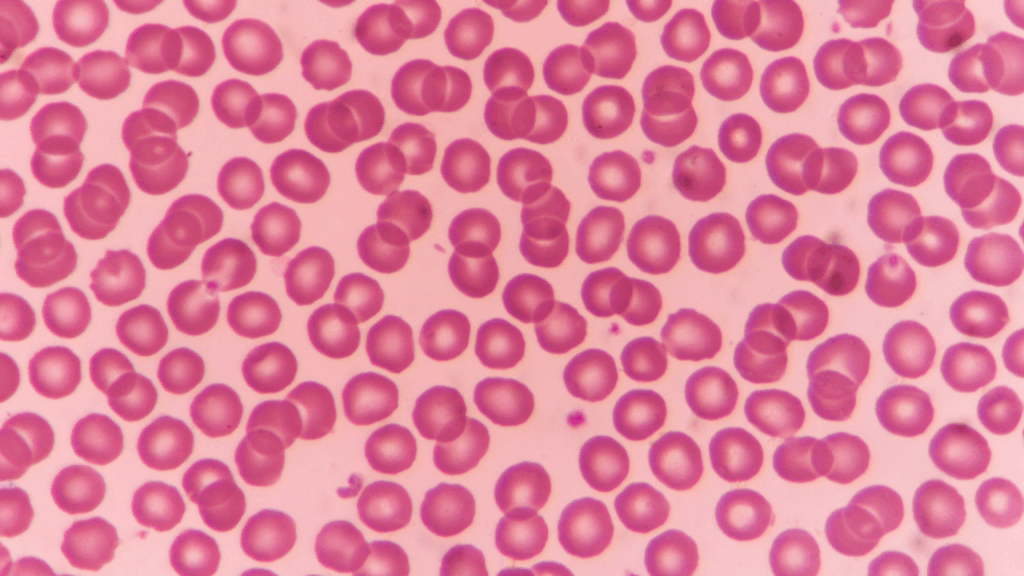

Una enfermedad rara que puede beneficiar a muchas áreas de la medicina.

La ataxia telangiectasia (A-T) tiene rasgos en común con muchas enfermedades neurológicas, y está relacionada con el cáncer… La investigación de la A-T beneficia a la investigación del cáncer ya que las mutaciones en el gen ATM, que causan la ataxia telangiectasia, són también causantes de muchos tipos de tumores.

La A-T está muy relacionada con el estudio del envejecimiento prematuro


Contamos con la plataforma global de datos genéticos y clínicos https://atfamilies.org/ (una iniciativa de la asociación americana ATCP, con el Instituto Broad del MIT y Harvard) que ha logrado la secuenciación del genoma completo de aproximadamente 400 pacientes con ataxia telangiectasia de todo el mundo y también recopila datos clínicos. Está a disposición de los investigadores.


Hay varios centros especializados en ataxia telangiectasia en todo el mundo. En ellos, un equipo coordinado de especialistas en Neurología, Inmunología, Neumología, Genética, Oftalmología, Dermatología, Psicología, Oncología… pasan revisión periódica conjunta de los niños y jóvenes con ataxia telangiectasia. Por ejemplo:
En España se están empezando a crear las primeras consultas interdisciplinarias en Sevilla, Barcelona y Madrid.


Las diferentes asociaciones de A-T en el mundo están unidas en la A-T Global Alliance, la alianza internacional.


Actualmente se está avanzando en la aplicación de la tecnología ASO (antisense oligonucleotides) para ataxia telangiectasia.


El papel fundamental de ATM en la señalización de daño en el ADN, y en concreto de roturas, despierta el interés en el campo de la reparación del ADN y la inestabilidad genética.


El gran tamaño del gen, que dificulta aproximaciones de terapia génica tradicionales, lo hace un candidato ideal para nuevas aproximaciones de corrección de mutaciones por edición génica.
Asociación Española Familia Ataxia Telangiectasia